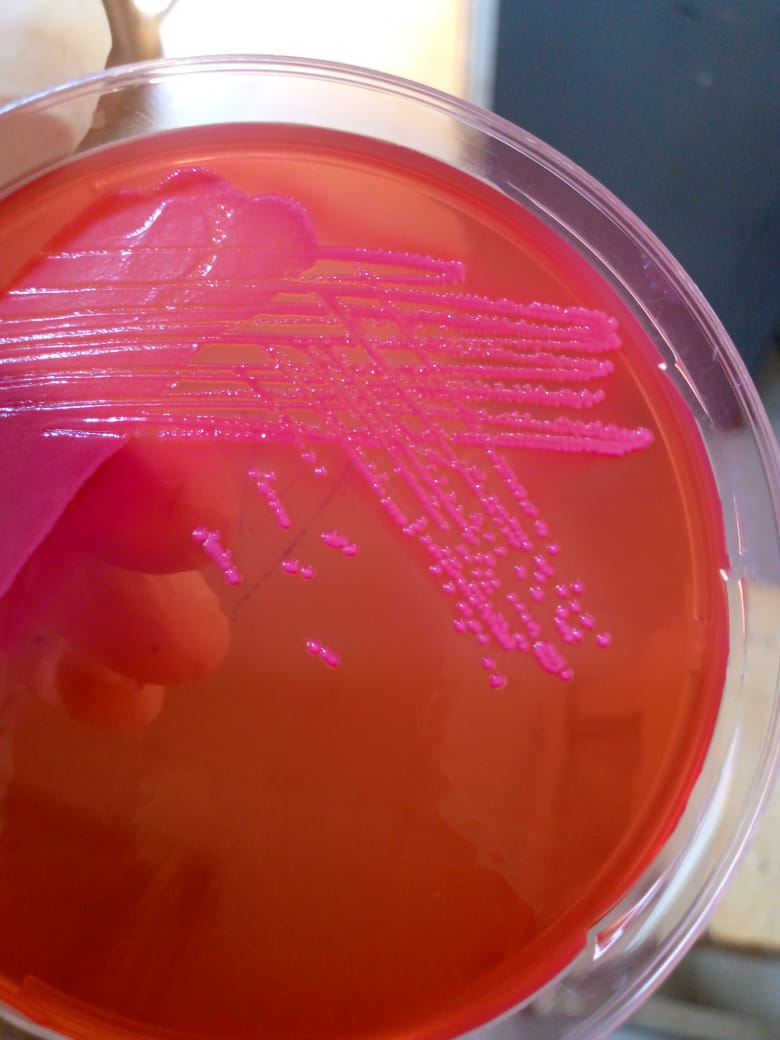
ShololaDamilol2's tweet image. Patient presented with mild free fluid in the pouch of Douglas following an induced abortion. Microbiological analysis revealed the isolation of E. coli from the vaginal fluid.

👉My objective remains to employ a multidisciplinary approach to enhance #reproductive health.
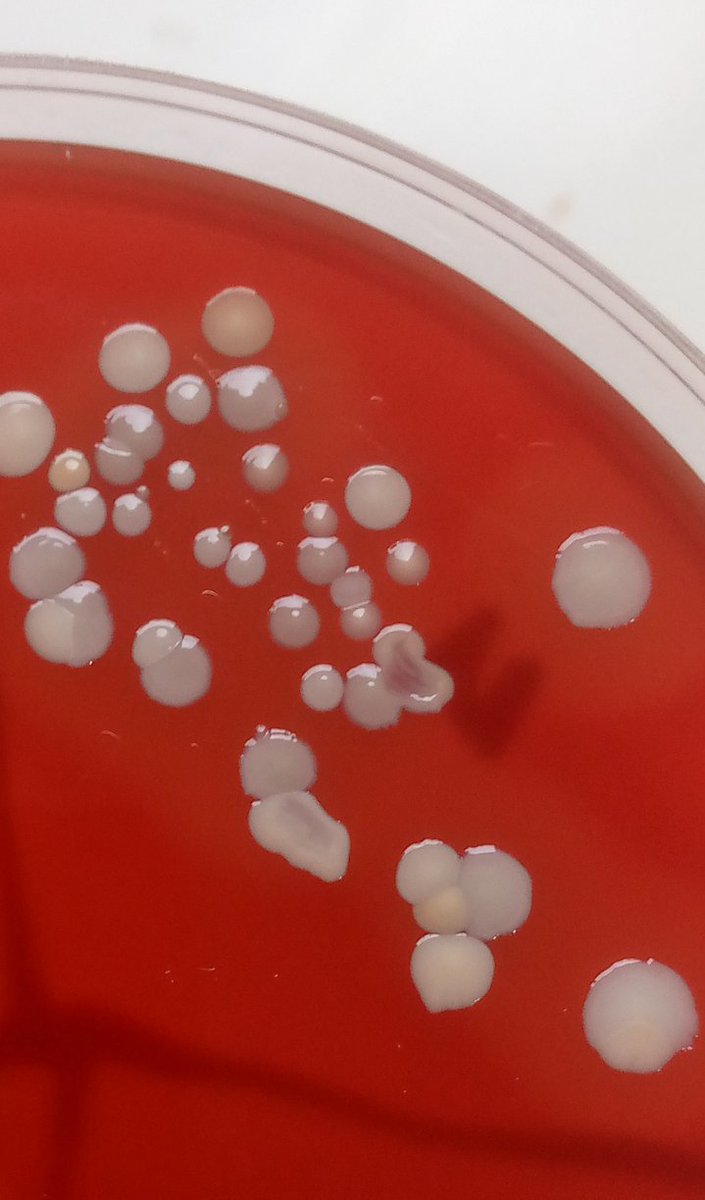
ShololaDamilol2's tweet image. From experience working with urogenital samples, I can tell that reproductive tract infections (RTIs) are already a significant public health concern in Nigeria. They contribute notably to both male and female infertility, as well as to a range of #reproductive complications

#reproductive search results
Female offspring who are conceived using assisted #reproductive technologies had an increased risk for #endometriosis and adenomyosis, as well as experiencing menstrual pain, pain during intercourse, and heavy menstrual bleeding. bit.ly/3K2eMXa
One of the reasons why women visit the hospital is due to #reproductive issues, with a significant number of these visits related to #vaginal infections or other #vaginal pathologies. Understanding your vaginal #microbiome is key step in treating any vagina infection.

In most cases, they’re a reassuring sign of good #male #reproductive health indianexpress.com/article/lifest…
.@fellow Health raises $24M to expand #reproductive testing services - company offers mail-in semen analysis and vasectomy testing | #menshealth #diagnostics mobihealthnews.com/news/fellow-he…
Young, fit and #infertile? Your #heart could be messing with your #reproductive system. Here's how and what you can do about it. @htTweets hindustantimes.com/lifestyle/heal…
Is 'Period Syncing' Real? Two Reproductive Health Experts Explain #'Period #Syncing' #Real? #Reproductive #Health #Experts #Explain #Vaccines #Pills #Doctor #Hospital #Pandemic dlvr.it/TRSSBf

Welcome back to a new year of the latest in #PlantScience! Our January cover features images from a study by Zhang et al., on the vital equilibrium between peptide and #hormone signaling required for #reproductive success in #plants. doi.org/10.1111/jipb.7… @WileyLifeSci #JIPB

A new study by Xiang et al. reveals that, for two #sympatric Parnassia species, pre-pollination barriers play a more significant role in #reproductive isolation than post-#pollination barriers. doi.org/10.1111/jse.13… @WileyEcolEvol #PlantSci #JSE #flower #development #endemism

#Flower color and scent attract #pollinators, but how do these complex interactions impact #reproductive success--and what role do these #insect attractants play in preventing #herbivory? Find out in a new study by Wang et al. doi.org/10.1111/jse.13… @WileyEcolEvol #PlantSci #JSE

The future of family building is here thanks to assisted #reproductive technologies. With all the advances, there are also important ethical questions that must be answered. Learn more by reading our #CASInsights Report. ow.ly/HfSu50W94I4

Click below to explore our collection of resources on #sexual and #reproductive health, which help pharmacists provide confidential advice and refer patients to related services #sexualhealth #reproductivehealth #ukpharmacy pharmaceutical-journal.com/sexual-health
On #Sexual & #Reproductive #HealthAwarenessDay, let’s remember: many #cancers are #preventable From HPV vaccination & regular cervical screening to STI prevention and informed reproductive choices — early action saves lives. Choose prevention. Protect the future.

#Austerity and #waiting times: Evidence on #reproductive health care delays among #young millennials in #deprived areas sciencedirect.com/science/articl… @m_marjim
One out of many excellent scientific activities @ESHRE is organising for its members and all those interested in #reproductive science. 🧬Discussing the limits in reproductive #genetictesting on 30/9, a webinar organised by @ESHREsigRG
🧩Join #ESHRE SIGs to explore key challenges in #ReproductiveMmedicine! 🔹16 Sep: Implantation & Early Pregnancy: facing barriers 🔹23 Sep: Embryology: fate of “unfit” embryos 🔹30 Sep: Reproductive Genetics: testing limits 🕔17:00–18:00 CEST eshre.eu/Education/Webi…



“But my #reproductive years are filled with constant #grief and "#whatifs."..It's untrue to say that I've fully grieved my situation": buff.ly/3MJ7RQl from @Popsugar #pregnancy #Chronicillness
Discriminatory #reproductive policies in #SouthKorea exclude single mothers and same-sex couples. Leading to restricted access to Parenthood, additionally #adoption rates have dropped by 80 percent in a decade: @sharonsthawaney or-f.org/33735
📰Published📰Salty start: How early-life #stress and #age change future #reproductive investment🐟️ buff.ly/YB74uJO
“#Endometriosis #pain isn’t isolated to #reproductive organs, it spreads beyond the pelvis. This pain feels like the insides are being pulled apart..bringing limitations to daily activities, work & intimacy": buff.ly/qhAOr3E By @lucjan44030893 #ChronicPain #ChronicIllness
🐟#EditorsChoice paper in #Fishes! Functional Involvement of Melatonin and Its Receptors in #Reproductive Regulation of the Marine Teleost, Large Yellow Croaker (Larimichthys crocea) 👉mdpi.com/2410-3888/10/1… 💦#melatoninreceptors #reproduction #GnRH #HPGaxis

Nta muntu n'umwe ukwiye kwiheza ubwe cg guhezwa kuri serivisi z'ubuzima bw'imyororokere! #OIPPARwanda #SRHR #reproductive #health #inclusion #BeyondBoundaries #imyororokere #ywcvs #SRHRInformation

Ababyeyi, abarimu n'abayobozi bakwiye gushyira imbaraga mu ruhare rwabo mu gushyigikira uburenganzira ku buzima bw'imyororokere bw'urubyiruko! #OIPPARwanda #SRHR #reproductive #health #inclusion #BeyondBoundaries #imyororokere #ywcvs #SRHRInformation

Duharanire kugira uruhare mu kunyomoza ibinyoma bivuga ku myororokere y'abantu bafite ubumuga! #OIPPARwanda #SRHR #reproductive #health #inclusion #BeyondBoundaries #imyororokere #ywcvs #SRHRInformation

The future of fertility care is evolving… and it starts with understanding the bigger picture. At #HegdeFertility, we believe that fertility is deeply connected to overall health—and conditions like #obesity play a crucial role in shaping #reproductive outcomes.
L’accouchement et la santé mentale font partie intégrante de la #santésexuelle et #reproductive. La #désinformation sur le post-partum isole, fait taire et retarde la prise en charge. #JeunesseInformée #AssociationSeReinES #EducationSanitaire #Hygeneforshe

"What’s driving this intense worldwide campaign for radical abortion? The #UnitedNations seems to be involved, using #innocuous-sounding banners like ‘#reproductive health’ and ‘#equality for women" creation.com/en/articles/ho…
Click below to explore our collection of resources on #sexual and #reproductive health, which help pharmacists provide confidential advice and refer patients to related services #sexualhealth #reproductivehealth #ukpharmacy pharmaceutical-journal.com/sexual-health

📰Published📰Increased #energetic cost of movement reduces #reproductive output in #zebrafish at different temperatures and water flow rates🐟️ buff.ly/zusxBE7
????!1!!2!2!!!1?1?1?!2 #NO #REPRODUCTIVE #SYSTEL !!!1!1!1!1
📢 “#Reproductive health counseling for #rheumatology patients of childbearing potential is essential,” Dr. Daniele Marcy @CUMedicalSchool, and colleagues wrote. Read the full story @HealioRheum 👇 vist.ly/4xive
Our mission to ensure that every woman has access to high-quality, dignified #reproductive healthcare is gaining momentum in #Moldova. 🤝Thank you @GreeceMFA🇬🇷 and all our partners for investing in reducing rural-urban inequalities and improving health outcomes for all women.
📣Quality maternal & #ReproHealth services—closer to all #women in🇲🇩 22 newly modernized gynecological offices launched in 11 primary healthcare centers, expanding access to essential care in hard-to-reach areas. 🙏#Greece 🇬🇷for supporting equitable & inclusive women’s health!




🔥 #Highly_Cited_Paper 📚 Per- and Polyfluoroalkyl Substances (#PFAS) Affect Female #Reproductive Health: #Epidemiological Evidence and Underlying Mechanisms 👨🔬by Rui Qu et al. 🧩brnw.ch/21x1fYL #female_reproduction #endocrine_disorders #pregnancy_complication

the #cellular and molecular mechanisms underlying the #reproductive performance of Mongolian #cattle… #Mongolia nature.com/articles/s4159…
Conventional in vitro fertilization at the age of fourties You can see the free full text of the research by Mete Işıkoğlu et al. Link : jtgga.org/pdf/a5223c9c-5… #advanced #reproductive #age #implantationrate #clinical #pregnancyrate #livebirth #rate

AH News: #Reproductive Ecology of #False #Coral #Snakes in #Brazil 🐍🇧🇷 #Museum specimens reveal size-driven reproductive #strategies and continuous breeding #patterns🏛️📔 🔗 Find out more --> oaj.fupress.net/index.php/ah/a…
The Heritage Foundation, which wrote Project 2025, released what's called Project 2026. The agenda is 2 ban abortion pills, criminalize mailing of abortion medication, establish fetal personhood & strip every fed safeguard protecting #reproductive freedom marytrump.org/p/the-unspeaka…
Diseases_MDPI Share the #Article by M. V. Lapresa-Alcalde, et al. #Reproductive Health Practices in Spanish Women Who Underwent Voluntary #Termination of #Pregnancy mdpi.com/2079-9721/11/1…

The Hidden Cycle Inside the Female Body #reproductive #science youtu.be/Pj_NbHDx6uA?si… via @YouTube

youtube.com
YouTube
Human Behaviour Physiology
Ikintu cya mbere ni amakuru ku buzima bwawe ndetse no ku byemezo ibyo ari byo byose wifataho cg wemera gufatirwa! @OIPPARwanda #SRHR #SpeakUp #reproductive #health #inclusion #BeyondBoundaries #imyororokere #ywcvs #girls #women #AmplifyChange #SRHRInformation

Today is the #WPD themed “empowering young people to create the families they want in a fair and hopeful world.” @UNFPA continues a relentless engagement in #RoK for #reproductive #agency. See the statement by @UNFPA Executive Director Dr. Natalia Kanem: bit.ly/4llF2cf




#Abortion bans perpetuate gender-based violence. These bans strip individuals of their autonomy, forcing many into dangerous situations and prolonged cycles of abuse. Join us this #16DaysOfActivism, and advocate for #reproductive rights in your community.

Causerie Éducative à Ouagadougou ! Le projet #CestLaVie2 renforce l’éducation des jeunes sur la #santésxuelle et #reproductive. Une rencontre sur la puberté et la reproduction a permis d’échanger sur l’acceptation de soi, l’hygiène et la prévention des risques. 👩🏽🏫👨🏾🏫




#Republicans in the legislature have passed laws limiting your right to seek care for your own body, and they're not going to stop if given a chance. #Vote for your own #reproductive rights - and if not yours, vote for your mother's, sister's, or daughter's freedom.

Editorial Connecting the Docs in Vasculitis Pregnancies 📖 doi.org/10.3899/jrheum… #pregnancy #reproductive #vasculitis

💡DYK? Human rights obligations require #EU member states to ensure that #sexual & #reproductive health services are: ✅Available ✅Accessible ✅Respectful ✅High quality How can the members of the @Europarl_EN advance #SRHR to meet these criteria? 👇 🔗reproductiverights.org/policy-brief-s…

One of the reasons why women visit the hospital is due to #reproductive issues, with a significant number of these visits related to #vaginal infections or other #vaginal pathologies. Understanding your vaginal #microbiome is key step in treating any vagina infection.

Patient presented with mild free fluid in the pouch of Douglas following an induced abortion. Microbiological analysis revealed the isolation of E. coli from the vaginal fluid. 👉My objective remains to employ a multidisciplinary approach to enhance #reproductive health.

#Flower color and scent attract #pollinators, but how do these complex interactions impact #reproductive success--and what role do these #insect attractants play in preventing #herbivory? Find out in a new study by Wang et al. doi.org/10.1111/jse.13… @WileyEcolEvol #PlantSci #JSE

From experience working with urogenital samples, I can tell that reproductive tract infections (RTIs) are already a significant public health concern in Nigeria. They contribute notably to both male and female infertility, as well as to a range of #reproductive complications
#WomensEqualityDay marks the anniversary of the 19th Amendment giving women the right to vote. But that was only the beginning of our fight for equality. Women’s rights – like the right to make our own healthcare decisions – are under attack. I fought to protect #reproductive

Dear @NoOnSB682 @CalRestaurants Do you want people to be serving up food contaminated with non-stick chemicals linked to #cancer, #immunesuppression, #reproductive harm? When heated, PFAS can flake into food & release toxic fumes. Its not safe! #SB682protects our health by

.@GavinNewsom, Robin McCoy—owner of Oak Grove Culinary Creations & the Lydia Project food truck—uses her business to train at-risk & special needs youth. ❤️ She warns: “This legislation would take money out of our business… creating hardship for small businesses.” #NoOnSB682
Sexual health and well-being are vital to #health across the life course, yet remain overlooked and underfunded This editorial explores approaches to prioritize inclusivity, autonomy and gender justice within the #sexual and #reproductive health framework. bit.ly/3ZRxrsp

Prof. Barchi, as part of a team led by Mackenzie Lawson (BS Public Health '23), published a new work "Exploring the drivers of #adolescent #sexual and #reproductive #healthcare-seeking behavior in northwestern Botswana: a cross-sectional analysis." bmcpublichealth.biomedcentral.com/articles/10.11…

New Diagnostic Tools for Early Endometriosis Detection. Endometriosis affects over 11% of women of reproductive age in the U.S. and 190 million women worldwide. bit.ly/3WVD0oi #WomensHealth #MedicalInnovation #Reproductive #Infertility #Healthcare #EarlyDetection

On #Sexual & #Reproductive #HealthAwarenessDay, let’s remember: many #cancers are #preventable From HPV vaccination & regular cervical screening to STI prevention and informed reproductive choices — early action saves lives. Choose prevention. Protect the future.

At #HRC57, join us for this panel on documenting #reproductive #violence, and the progress, opportunities, and challenges that these documentation efforts currently face. 📍 Where: @UNGeneva, Room VIII 📅When: Sept. 30, at 3PM CEST ✒️Registration: lnkd.in/e2TyvAWA

Fieldfisher @Fieldfisher launches #reproductive and #familyhealthplatform for #UKstaff bit.ly/4kFecvN #familyhealth

The influence of the gut #microbiome extends beyond GI health, impacting many other bodily systems as well Which is why we'll be presenting 2 posters on #reproductive #endocrinology at #ENDO2024 this weekend! #PCOS #testosterone @TheEndoSociety @CedarsSinaiMed

📌 The @EASOobesity has published a landmark position statement addressing care for #women living with #obesity throughout their #reproductive life - from #fertility and #preconception to #pregnancy, and the #postpartum period. 🖇️ easo.org/supporting-wom…




Something went wrong.
Something went wrong.
United States Trends
- 1. #WWERaw N/A
- 2. Pistons N/A
- 3. Cade N/A
- 4. Duren N/A
- 5. Jamal Cain N/A
- 6. Magic N/A
- 7. Desmond Bane N/A
- 8. Devin Booker N/A
- 9. Jalen Suggs N/A
- 10. Tobias Harris N/A
- 11. World War Eleven N/A
- 12. Duncan Robinson N/A
- 13. Kimmel N/A
- 14. #TheRookie N/A
- 15. Backlash N/A
- 16. JB Bickerstaff N/A
- 17. PLAY THE SONG N/A
- 18. #LetsGoPens N/A
- 19. Tyus Jones N/A
- 20. Franz N/A

































































































